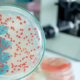

TL-07 Nuovo emettitore da banco per PDT
Il modello TL-07 è un emettitore LED da banco progettato per applicazioni di terapia fotodinamica (PDT).
Il dispositivo utilizza 60 LED HiPower a 630 nm, garantendo un’elevata efficienza ottica e un’irradiazione uniforme sull’area di trattamento.
Con un’irradianza di 160 mW/cm² a 30 cm e un’energia totale di 96 J/cm² in 10 minuti, TL-07 assicura prestazioni costanti e affidabili in ambito clinico e di laboratorio.
Il sistema consente la regolazione dei parametri di emissione tramite pannello touch screen o telecomando remoto, offrendo un’interfaccia intuitiva e precisa.
Caratteristiche principali
- Emissione a 630 nm mediante 60 LED HiPower
- Alimentazione: 100–240 V AC, 50–60 Hz
- Irradianza: 160 mW/cm² a 30 cm (96 J/cm² in 10 min)
- Angolo di emissione: 30°
- Area coperta: 40 × 30 cm a 150 mm
- Timer di emissione: 0–30 minuti
- Regolazione potenza di emissione: 0–100%
- Frequenza di emissione: continua o modulata a 10 kHz
Scopri di più cliccando qui.